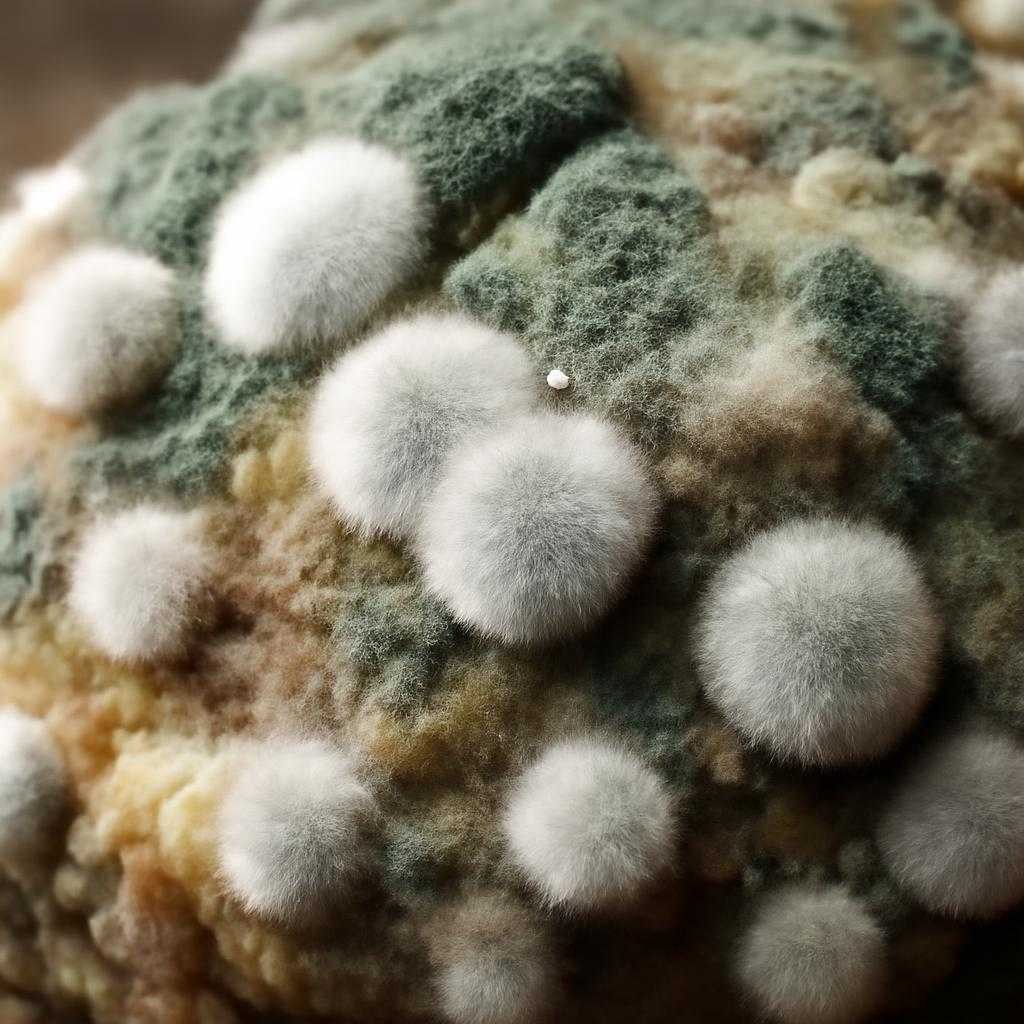
плесень

Плесень в доме: как убрать очаги и перекрыть путь сырости
Я много лет работаю с домами после протечек, ошибок утепления, неудачной вентиляции и сырого ремонта. Плесень не возникает сама по себе: у неё всегда есть корм, влага и тихий угол, где воздух почти не движется. Чёрные точки на откосе, серый бархат в углу, зеленоватый налёт под ванной, бурые разводы у плинтуса — разные формы одной проблемы. Споры живут в воздухе постоянно, но в сухой и чистой оболочке дома они не собираются в колонию. Когда поверхность сыреет, отделка превращается для грибка в стол.
От плесени нельзя избавиться одной только «химией». Если промыть пятно и оставить прежнюю сырость, колония вернётся по старым дорожкам. Я видел стены, которые обрабатывали сильным составом три раза за сезон, а источник сидел в промёрзшем углу, где точка росы уходила внутрь штукатурного слоя. Точка росы — температура, при которой водяной пар переходит в воду. Когда тёплый влажный воздух касается холодной зоны, на поверхности или в толще конструкции выпадает конденсат. Для грибка такая зона — оазис в миниатюре.
Где искать причину
Сначала я смотрю не на пятно, а на сценарий его появления. Плесень в ванной возле швов часто связана с застойной влагой и слабой вытяжкой. Колонии на откосах и в углах наружных стен говорят о переохлаждении конструкции, продувание монтажного шва, пустотах в утеплении. Пятна под обоями у пола нередко приходят из стяжки, сырого подвала, капиллярного подсоса из кладки. Капиллярный подсос — движение влаги по мелким порам материала вверх, словно вода тянется по фитилю. В старом фонде я встречал сыреющие стены без единой протечки сверху: вода поднималась из ффундамента и держала штукатурку во влажном состоянии месяцами.
Отдельная история — свежий ремонт. Когда шпатлёвка, стяжка, штукатурка и краска закрыты раньше полного высыхания, дом начинает дышать сырым паром. Внешне отделка выглядит аккуратно, а под ней запускается тихая биология. Ещё один частый источник — плотная мебель у холодной стены. Шкаф перекрывает обдув, в узком зазоре воздух застывает, поверхность стынет, и грибок ползёт по стене, как тень от сырости.
Чтобы найти причину без гадания, я проверяю четыре вещи: протечки, вентиляцию, температуру поверхностей и скрытую влажность материалов. Протечки видны по трассам труб, сифоном, примыкания ванны, крыше, подоконным зонам, межпанельным швам. Вентиляцию оценивают не листком бумаги у решётки, а состоянием каналов, притоком воздуха и реальным удалением влаги после душа, готовки, сушки белья. Температуру поверхности удобно смотреть тепловизором. Он сразу показывает мостики холода — участки, через которые тепло уходит быстрее обычного. Мостик холода — слабое место ограждающей конструкции, где температура падает сильнее, чем вокруг. Влажность основания измеряют влагомером, по ощущениям рука почти всегда врёт.
Снятие очага
Перед работой я изолирую зону. Споры легко разносятся по комнатам, поэтому двери закрываю, на проход вешаю плёнку, окна открываю на проветривание, но без сильного сквозняка через квартиру. На руках — перчатки, на лице — респиратор класса не ниже FFP2, на глазах — защита. Простая тканевая маска против спор слаба. Если поражён гипсокартон, рыхлая штукатурка, бумажные обои, минеральная вата, ковролин с пропиткойпитавшейся подложкой, я не трачу время на косметику: такие материалы после глубокого заражения проще удалить. Органика, набравшая влагу, держит мицелий внутри структуры. Мицелий — грибница, тонкая сеть нитей, из которой растёт колония. Снаружи виден лишь её флаг.
Гладкие основания — плитка, стекло, металл, плотный пластик — очищаются легче. Сначала убираю видимый налёт механически: щёткой, шпателем, салфетками, которые сразу отправляются в пакет. Сухой соскоб без контроля пыли нежелателен: споры разлетаются, как семена. Поверхность лучше слегка увлажнить рабочим раствором, чтобы налёт не пылил. Дальше идёт обработка фунгицидом. Фунгицид — состав, подавляющий грибок и его споры. Для минеральных оснований подходят специализированные средства для санирующей обработки. Хлорсодержащие растворы убирают окраску колонии, но на пористых стенах работают грубо и неглубоко: запах силён, красящий эффект заметен быстро, а корень сырости остаётся на месте. На дереве нужна аккуратность вдвойне: часть составов жжёт волокно, меняет тон и поднимает ворс.
Если поражение глубже отделки, я раскрываю участок до чистого и прочного слоя. Пятно на краске — далеко не всегда пятно на краске. Под ним нередко живёт влажная шпаклёвка, рыхлая штукатурка, мокрый газобетон. Основание просушивают, потом повторно обрабатываю и даю время на полное высыхание. Спешка здесь похожа на укладку плитки по льду: внешне ровно, держится недолго. Когда зона высохла, выполняю восстановление: санирующая штукатурка, шпатлевание, грунт, финиш. Санирующая штукатурка отличается пористой структурой: она отводит влагу и соли из основания мягче, чем плотные смеси. Для сырых стен такой слой работает как буфер, а не как крышка на кастрюле.
Если плесень сидит в межплиточных швах, старую затирку вынимаю полностью на поражённом участке, промываю и обеззараживаю основание, сушу, затем наношу новую затирку с гидрофобными свойствами. Гидрофобность — способность материала отталкивать воду. Герметик вокруг ванны и раковины, покрытые чёрным налётом, чаще выгоднее заменить, чем бесконечно отбеливать. Силикон стареет, в микропорах поселяется грибок, сцепление с бортом ванны ослабевает, и под шов начинает затекать вода.
Перекрыть возврат
После удаления очага дом нужно лишить сырого убежища. В ванной и кухне я первым делом нормализуют воздухообмен. Вытяжной канал прочищают, вентилятор подбирают по объёму помещения и режима влагоудаления, дверной зазор или переточная решётка дают воздуху маршрут к вытяжке. Без притока даже сильный вентилятор часто шумит впустую. Если окна герметичные, а наружный воздух в комнаты почти не поступает, внутри растёт влажность, и стены постепенно переходят в режим холодного стекла.
Следующий узел — утепление и герметичность контура. Угол, который промерзает каждую зиму, лечат не обогревателем у плинтуса, а корректировкой конструкции: утеплением снаружи, восстановлением межпанельного шва, заделкой пустот, исправлением откоса, нормальной установкой подоконного узла. Внутреннее утепление без расчёта часто загоняет точку росы глубже в стену и рождает скрытую сырость. Снаружи дом держит тепло как тёплая куртка, изнутри без понимания физики легко получить термос с мокрой подкладкой.
В подвальных и первых этажах я часто устраняю капиллярный подсос через отсечную гидроизоляцию. Отсечная гидроизоляция — барьер, который перекрывает подъём влаги из нижней части стены. В кирпичных и каменных домах для такой задачи применяют инъекционные составы: в стене бурят ряд отверстий и вводят гидрофобизирующий гель, формирующий внутренний водоотталкивающий пояс. Работа ювелирная, зато у сырости исчезает вертикальная лестница.
Для деревянных домов картина иная. Плесень там любит подполье, торцы лаг, места у продухов, холодные карманы в узлах примыкания. Дерево после обработки фунгицидом пропитывают антисептиком глубокого проникновения и нередко усиливают вентиляцию подпольного пространства. Если поражение дошло до гнили, вопрос уже не в косметике, а в несущей способности элемента. Гниль и плесень — соседи, но не близнецы: первая разрушает прочность, вторая часто сигнализирует о режиме, при котором разрушение уже рядом.
В повседневном режиме дома я держу под контролем влажность воздуха. Для жилых комнат комфортен умеренный диапазон, без липкой духоты и без пересушивания. Когда бельё сушат в комнате без проветривания, когда вытяжка молчит во время готовки, когда после душа дверь в ванную закрыта наглухо, стены медленно набирают воду из воздуха. Гигрометр здесь полезнее догадок. Небольшой прибор быстро показывает, чем живёт помещение, и снимает спор между «кажется сухо» и «почему снова темнеет угол».
Профилактика без мифов
Я не советую закрашивать плесень плотной краской в надежде, что проблема исчезнет под белым слоем. Краска прячет симптом, а сырость продолжает работу. Не советую и бесконечно мыть заражённый участок уксусом, содой, эфирными маслами и прочей бытовой алхимией, когда под отделкой мокрая стена или течёт шов. Дом не обмануть ароматами. Если источник влаги жив, плесень возвращается тихо, но упрямо.
Есть смысл пересмотреть мебельную расстановку у наружных стен, оставить зазор для обдува, не прижимать крупные шкафы вплотную к холодным углам. В санузле полезны короткие циклы проветривания после водных процедур, сухие швы, исправный вентилятор, чистые решётки. На кухне важна работа вытяжки именно в процессе готовки, а не после того, как пар уже осел на потолке. В новостройках и после мокрых работ я закладываю время на естественную сушку конструкций. Быстрый финиш по сырому основанию выглядит эффектно лишь до первого холодного сезона.
Когда площадь заражения велика, запах затхлости въелся в дом, а пятна проступают в разных комнатах, я провожу обследование глубже: смотрю кровлю, чердак, фасад, межэтажные узлы, канализацию, состояние утеплителя, пароизоляции, примыканий окон. Пароизоляция — слой, сдерживающий переход водяного пара в конструкцию. Ошибка в её расположении работает как перевёрнутый зонт: формально плёнка есть, а вода оказывается там, где её не ждали. В каркасных домах такая мелочь быстро превращается в длинную историю с разборкой отделки.
Плесень похожа на копоть от скрытого пожара: пятно видно на поверхности, а причина часто сидит глубже и живёт по законам физики, а не уборки. Когда найден источник влаги, удалён заражённый слой, просушена конструкция и восстановлен нормальный воздухообмен, дом перестаёт кормить грибамибок. И тогда стены пахнут отделкой, деревом, чистым воздухом — чем угодно, кроме сырого подвала, который однажды пробрался в жилое пространство.
Автор статьи